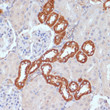
Immunohistochemistry analysis of PDGFRB in paraffin-embedded rat kidney using PDGFRB Rabbit polyclonal antibody (STJ24938) at dilution of 1:100 (40x lens). Perform microwave antigen retrieval with 10 mM PBS buffer pH 7. 2 before commencing with immunohistochemistry staining protocol.

| Post Translational Modifications | Autophosphorylated on tyrosine residues upon ligand binding. Autophosphorylation occurs in trans, i.e. one subunit of the dimeric receptor phosphorylates tyrosine residues on the other subunit. Phosphorylation at Tyr-579, and to a lesser degree, at Tyr-581, is important for interaction with SRC family kinases. Phosphorylation at Tyr-740 and Tyr-751 is important for interaction with PIK3R1. Phosphorylation at Tyr-751 is important for interaction with NCK1. Phosphorylation at Tyr-771 and Tyr-857 is important for interaction with RASA1/GAP. Phosphorylation at Tyr-857 is important for efficient phosphorylation of PLCG1 and PTPN11, resulting in increased phosphorylation of AKT1, MAPK1/ERK2 and/or MAPK3/ERK1, PDCD6IP/ALIX and STAM, and in increased cell proliferation. Phosphorylation at Tyr-1009 is important for interaction with PTPN11. Phosphorylation at Tyr-1009 and Tyr-1021 is important for interaction with PLCG1. Phosphorylation at Tyr-1021 is important for interaction with CBL.PLCG1 and CBL compete for the same binding site. Dephosphorylated by PTPRJ at Tyr-751, Tyr-857, Tyr-1009 and Tyr-1021. Dephosphorylated by PTPN2 at Tyr-579 and Tyr-1021. N-glycosylated. Ubiquitinated. After autophosphorylation, the receptor is polyubiquitinated, leading to its degradation. |
| Function | Tyrosine-protein kinase that acts as a cell-surface receptor for homodimeric PDGFB and PDGFD and for heterodimers formed by PDGFA and PDGFB, and plays an essential role in the regulation of embryonic development, cell proliferation, survival, differentiation, chemotaxis and migration. Plays an essential role in blood vessel development by promoting proliferation, migration and recruitment of pericytes and smooth muscle cells to endothelial cells. Plays a role in the migration of vascular smooth muscle cells and the formation of neointima at vascular injury sites. Required for normal development of the cardiovascular system. Required for normal recruitment of pericytes (mesangial cells) in the kidney glomerulus, and for normal formation of a branched network of capillaries in kidney glomeruli. Promotes rearrangement of the actin cytoskeleton and the formation of membrane ruffles. Binding of its cognate ligands - homodimeric PDGFB, heterodimers formed by PDGFA and PDGFB or homodimeric PDGFD -leads to the activation of several signaling cascades.the response depends on the nature of the bound ligand and is modulated by the formation of heterodimers between PDGFRA and PDGFRB. Phosphorylates PLCG1, PIK3R1, PTPN11, RASA1/GAP, CBL, SHC1 and NCK1. Activation of PLCG1 leads to the production of the cellular signaling molecules diacylglycerol and inositol 1,4,5-trisphosphate, mobilization of cytosolic Ca(2+) and the activation of protein kinase C. Phosphorylation of PIK3R1, the regulatory subunit of phosphatidylinositol 3-kinase, leads to the activation of the AKT1 signaling pathway. Phosphorylation of SHC1, or of the C-terminus of PTPN11, creates a binding site for GRB2, resulting in the activation of HRAS, RAF1 and down-stream MAP kinases, including MAPK1/ERK2 and/or MAPK3/ERK1. Promotes phosphorylation and activation of SRC family kinases. Promotes phosphorylation of PDCD6IP/ALIX and STAM. Receptor signaling is down-regulated by protein phosphatases that dephosphorylate the receptor and its down-stream effectors, and by rapid internalization of the activated receptor. |
| Protein Name | Platelet-Derived Growth Factor Receptor BetaPdgf-R-BetaPdgfr-BetaBeta Platelet-Derived Growth Factor ReceptorBeta-Type Platelet-Derived Growth Factor ReceptorCd140 Antigen-Like Family Member BPlatelet-Derived Growth Factor Receptor 1Pdgfr-1Cd Antigen Cd140b |
| Database Links | Reactome: R-HSA-1257604Reactome: R-HSA-186763Reactome: R-HSA-186797Reactome: R-HSA-2219530Reactome: R-HSA-5673001Reactome: R-HSA-6811558 |
| Cellular Localisation | Cell MembraneSingle-Pass Type I Membrane ProteinCytoplasmic VesicleLysosome LumenAfter Ligand BindingThe Autophosphorylated Receptor Is Ubiquitinated And InternalizedLeading To Its Degradation |
| Alternative Antibody Names | Anti-Platelet-Derived Growth Factor Receptor Beta antibodyAnti-Pdgf-R-Beta antibodyAnti-Pdgfr-Beta antibodyAnti-Beta Platelet-Derived Growth Factor Receptor antibodyAnti-Beta-Type Platelet-Derived Growth Factor Receptor antibodyAnti-Cd140 Antigen-Like Family Member B antibodyAnti-Platelet-Derived Growth Factor Receptor 1 antibodyAnti-Pdgfr-1 antibodyAnti-Cd Antigen Cd140b antibodyAnti-PDGFRB antibodyAnti-PDGFR antibodyAnti-PDGFR1 antibody |